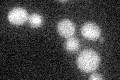
YGL099W
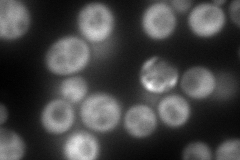
YGL099W
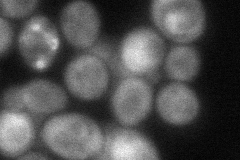
YGL099W

View description
Putative GTPase involved in 60S ribosomal subunit biogenesis; required for the release of Nmd3p from 60S subunits in the cytoplasm
Localization:
Intensity:
Fold change:
Significance:
-
C’ GFP library in SD
below threshold16.3 -
N' NOP1pr-GFP in SD

cytosol176.015 -
N' TEF2pr-mCherry in SD
cytosol232.114 -
N' NATIVEpr-GFP in SD

cytosol42.8747 -
N' TEF2pr-VC and Cyto-VN in SD
cytosol54.815 -
C’ GFP library in SD+DTT

cytosol17.511.07No -
C’ GFP library in SD+H2O2

cytosol16.280.99No -
C’ GFP library in Starvation Media

cytosol15.60.95No -
C’ GFP library on the background of Pup2-DaMP

below threshold -
C’ GFP library on the background of CCT mutant

below threshold17.78751.09092No
